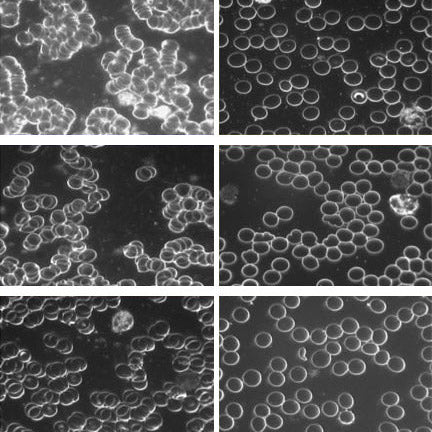
Earthing Book | Ober, C. | Groundology | Raw Living UK | Books | 'Earthing: The Most Important Health Discovery Ever?' by Clinton Ober explores the transformative health effects of connecting with the bare earth.

Earthing Book (Clinton Ober)
Earthing Book (Clinton Ober)
- Free UK delivery on orders over £65
Description
Description
EARTHING, the most eye-opening book to appear in decades, introduces the planet's powerful, amazing and overlooked natural healing energy and how people anywhere can readily connect to it. The never-before-told story filled with fascinating research and real-life testimonials chronicles a discovery of the first magnitude with potential to create a global health revolution.
Throughout most of evolution humans walked barefoot and slept on the ground, largely oblivious to the fact that the surface of the Earth contains limitless healing energy. Science has discovered this energy as free-flowing electrons constantly replenished by solar radiation and lightning strikes. Few people know it, but the ground provides a subtle electric signal that maintains health and governs the intricate mechanisms that make our bodies work just like plugging a lamp into a power socket makes it light up. Modern lifestyles, including the widespread use of insulative rubber or plastic soled shoes, has disconnected us from this energy and, of course, we no longer sleep on the ground as we did in times past.
EARTHING describes how this physical disconnection from the Earth creates abnormal physiology and contributes to inflammation, pain, fatigue, stress and poor sleep, and how by reconnecting to the Earth symptoms are rapidly relieved and even eliminated.
Podcast & Videos
Podcast & Videos
Click here to play the podcast interview with Groundology founder Seb Francis. Seb tells us how his interest in grounding began, why grounding is so beneficial, how to do it naturally, and shares information on the different grounding products that are on offer.